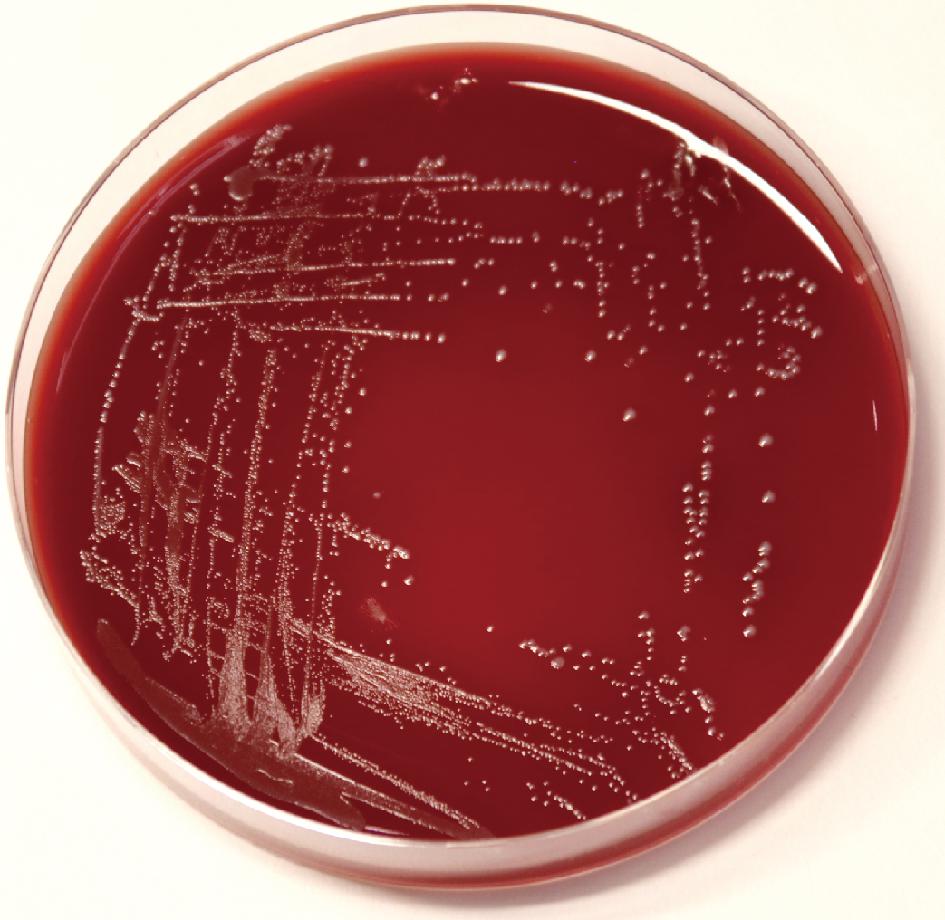

高尿酸血症是一种因嘌呤代谢紊乱和尿酸形成与分泌失衡引发的代谢性疾病,也是导致痛风、动脉硬化和心血管等疾病发生的重要危险因素之一[1-2]。目前,针对该病的治疗方法主要包括饮食干预和药物治疗,但因人群饮食控制难度较大,且药物所产生的副作用偏多[3-4],因此,寻找温和、无毒副作用的方式有效降低高尿酸血症患者的血清尿酸水平已成为目前该领域研究的热点问题。
近几年,相关研究发现乳酸菌可通过调节肠道菌群平衡、增强免疫防御系统、保持肠道屏障完整等方式对高尿酸血症和痛风进行积极的调控[5-7],短乳杆菌作为一类重要的乳酸菌,其在高尿酸血症的治疗过程中同样扮演重要角色。LEE等[8]研究发现短乳杆菌MJM60390具有较强的核苷降解能力,高尿酸血症小鼠口服该菌2周后,血清中尿酸水平相比模型组显著降低,尿酸合成过程中的关键酶,即黄嘌呤氧化酶(xanthine oxidase, XOD),活力被抑制30%,体内肾小球和肾小管等相关组织损伤情况得到一定改善,但肾脏功能指标即肌酐和尿素氮的表达水平,相比模型组并无显著升高。WANG等[9]研究发现,短乳杆菌DM9218基因组中存在肌酐水解酶基因,用该菌株干预高尿酸血症小鼠8周后,其血清尿酸水平相比模型组显著降低,XOD活力也得到明显抑制。然而,目前针对高尿酸血症具有益生功效的短乳杆菌仍少有报道,更多短乳杆菌的降尿酸特性及潜力还有待挖掘。
乳酸菌作为益生菌应用于高尿酸血症预防和治疗中,首先需考虑其安全性。少量研究发现,乳酸菌菌株在某些特殊情况下会变成条件致病菌,当在一些特殊个体(如新生儿或老年人)中应用时存在引发肺炎、心膜炎和败血症的风险;此外,部分乳酸菌也会携带可转移的抗生素抗性基因[10-11],因此,明确菌株安全性十分必要。目前,针对具有降尿酸功效的乳酸菌开展安全性评价的研究尚不全面,更多研究亟待深入。
本课题组前期从传统发酵泡菜中分离得到一株短乳杆菌(Lactobacillus brevis)SLlac-18,体外实验结果表明该菌株对核苷的降解率可高达97%以上,并且可有效抑制XOD活力,对高尿酸血症可能具有一定预防和辅助治疗作用[12]。为进一步分析短乳杆菌SLlac-18对高尿酸血症的治疗功效,本研究首先对菌株进行体内安全性评价,之后通过开展体内实验探究了该菌株对高尿酸血症小鼠的益生功能,并对可能的机制进行了初步探讨。
1 材料与方法
1.1 材料与试剂
1.1.1 菌株来源
短乳杆菌SLlac-18为本课题组前期自传统发酵泡菜中筛选分离所得。
1.1.2 药品及试剂
MRS培养基,青岛海博生物技术有限公司;尿酸测试盒、尿素氮(blood urea nitrogen, BUN)测试盒、肌酐(creatinine, CRE)测试盒、谷草转氨酶(aspartate aminotransferase, AST)测试盒、谷丙转氨酶(alanine aminotransferase, ALT)测试盒、丙二醛(malondialdehyde, MDA)测试盒,南京建成生物工程研究所;XOD活力检测试剂盒,北京索莱宝科技有限公司;小鼠TNF-α酶联免疫分析试剂盒、小鼠IL-1β酶联免疫分析试剂盒,安迪基因生物科技有限公司;氧嗪酸钾盐,西格玛奥德里奇(上海)贸易有限公司;反转录试剂盒、qPCR试剂盒,诺唯赞生物科技股份有限公司;动物全蛋白提取试剂盒、蛋白酶抑制剂、二辛可酸(bicinchoninic acid,BCA)蛋白质定量检测试剂盒、SDS-PAGE变性丙烯酰胺凝胶快速制备试剂盒、放射免疫沉淀法(radio immunoprecipitation assay,RIPA)裂解液,生工生物工程(上海)股份有限公司;一抗:β-actin、GLUT9、NPT1,二抗:山羊抗兔抗体,艾比玛特医药科技(上海)有限公司;苏木精-伊红高清恒染试剂盒,武汉赛维尔生物科技有限公司。
1.2 仪器与设备
Multifuge X1R高速冷冻低温离心机,Thermo Fisher公司;Epoch超微量微孔板检测系统,安捷伦科技(上海)有限公司;SW-CJ-1FD超净工作台、BG-80电热恒温培养箱,上海博迅实业有限公司;C1000实时定量PCR仪,Bio-Rad公司;TANON5200MULT1蛋白荧光成像系统,上海天能生命科学有限公司。
1.3 实验方法
1.3.1 短乳杆菌SLlac-18的培养与菌液制备
将短乳杆菌SLlac-18菌株接种于MRS肉汤培养基中静置培养24 h,培养温度为37 ℃;将细菌悬液离心后,弃掉上清液并收集菌体沉淀,如此反复操作3~4次;之后,用生理盐水洗涤沉淀2次,将菌液浓度调至1.0×109 CFU/mL以备后期小鼠干预使用。
1.3.2 短乳杆菌SLlac-18的安全性评价
1.3.2.1 短乳杆菌SLlac-18溶血活性分析
取活化的短乳杆菌SLlac-18菌悬液划线于绵羊血平板上,于37 ℃恒温培养箱中培养48 h后,观察菌落周围颜色变化,判断是否有溶菌环出现。
1.3.2.2 动物体内安全性试验
依据贾盛等[13]的方法,参照农业农村部制定的《直接饲喂微生物和发酵制品生产菌株鉴定及其安全性评价指南》对短乳杆菌SLlac-18安全性开展动物体内评价。动物实验严格遵照佳木斯大学公共卫生学院伦理委员会所制定的伦理学标准(伦理委员会审查编号:230802198904150526)
将10只6周龄的雄性昆明小鼠适应性培养1周后随机分为2组,对照组小鼠每天灌胃300 μL生理盐水,实验组小鼠每天灌胃300 μL浓度为1.0×109 CFU/mL短乳杆菌SLlac-18活菌液,持续灌胃14 d,期间小鼠均自由采食和饮水,每2 d记录小鼠体重变化,并对小鼠精神状态及排泄物状况进行观察。灌胃结束后,采集小鼠血液进行血细胞指标分析,将小鼠安乐死后取肝脏、肾脏和脾脏称重,计算脏器指数,选取部分肝脏和肾脏组织固定于质量分数为4%多聚甲醛溶液中保存以用于病理学分析。
1.3.3 短乳杆菌SLlac-18对高尿酸血小鼠益生功能评价
1.3.3.1 动物实验设计
将24只6周龄雄性小鼠随机分为3组,即对照组、高尿酸血症模型组(模型组)、短乳杆菌SLlac-18干预组(活菌组)。实验动物饲养温度为(23±2) ℃,相对湿度为55%~65%,昼夜12 h交替,期间自由进食和饮水适应1周后,于第2周开始除对照组外,模型组和活菌组小鼠饮食由基础饲料全部更换为高嘌呤饲料(10%酵母+0.25%腺嘌呤,质量分数),此外,2组小鼠每天腹腔注射1次300 mg/kg的氧嗪酸钾,对照组腹腔注射等体积的生理盐水,活菌组小鼠还需每日灌胃300 μL浓度为1.0×109 CFU/mL短乳杆菌SLlac-18。实验开始第5周,麻醉小鼠对其进行眼部静脉丛取血,颈椎脱臼处死后采集肝脏和肾脏,除部分组织固定于质量分数为4%多聚甲醛溶液中保存以用于病理学分析,其余组织样本均置于液氮中迅速冷冻后于-80 ℃冰箱中冻藏,以便用于后续实验。血液样本于4 ℃,4 000 r/min离心20 min后取上清液同样置于-80 ℃冰箱中保存。
1.3.3.2 小鼠血清生化指标分析
采用试剂盒提供的方法对小鼠血清中尿酸、CRE、BUN和MDA含量,以及AST、ALT和XOD活力进行测定。
1.3.3.3 肝脏和肾脏病理学检测
收集小鼠的肝脏和肾脏组织,将其放置于质量分数为4%的多聚甲醛溶液中固定72 h。采用常规石蜡包埋技术制作组织切片,然后用苏木精-伊红染色。观察各组小鼠肝肾组织所发生的形态学变化。
1.3.3.4 实时荧光定量PCR分析
利用Trizol法提取小鼠肾脏组织总RNA,并对其浓度和纯度进行测定,利用反转录试剂盒获取得到cDNA,以此为模板进行实时定量PCR反应,反应体系为:SYBR qPCR Master Mix 10 μL,RNase Free water 8.2 μL,上、下游引物各0.4 μL(10 μmol/L),cDNA 1 μL。反应条件为:预变性95 ℃ 30 s,变性95 ℃ 10 s,退火60 ℃ 30 s,共计40个循环;反应以actin-β为内参基因,采用2-ΔΔCT法计算各目的基因mRNA的相对表达水平。PCR引物序列见表1。
表1 实时定量PCR引物序列
Table 1 Real-time quantitative PCR primer sequence

基因名称引物名称引物序列葡萄糖转运蛋白(GLUT9)正向引物(5′-3′)TGCATTGGCGTGTTTTCTGG反向引物(5′-3′)GGAAGGCTTTCATGGCTCCT钠依赖性磷酸转运蛋白(NPT1)正向引物(5′-3′)GCCATGGTGAACAACACAGG反向引物(5′-3′)GAGCCTGAACCACGACCATA
1.3.3.5 Western Blot检测蛋白表达水平
取小鼠肾组织10 mg,依据动物全蛋白提取试剂盒所提供的方法进行操作,待组织全部溶解后,经12 000 r/min,离心5 min后,留取上清液,即得总蛋白溶液,并按照BCA蛋白质定量检测试剂盒测定总蛋白浓度,根据结果将样品用RNase Free water稀释成同一浓度。取等体积蛋白样品溶液经凝胶电泳、转膜、脱脂牛奶封闭、孵育一抗、洗膜、孵育二抗、洗膜、DAB显色等操作后,置于凝胶成像分析系统检测并拍照。β-actin、GLUT9和NPT1这3种一抗均按体积比1∶1 000稀释,二抗按照体积比1∶2 000稀释。
1.4 数据处理
利用GraphPad Prism 9.0版软件进行数据分析,并对实验结果进行作图。计量资料以“平均值±标准差”表示,2组之间均数比较采用非配对t检验,以P<0.05为差异有统计学意义。
2 结果与分析
2.1 短乳杆菌SLlac-18安全性评价结果
2.1.1 短乳杆菌SLlac-18的溶血活性
由图1可知,短乳杆菌SLlac-18于绵羊血平板上生长状况良好,菌落周围无溶血环,该菌株无溶血活性。
图1 短乳杆菌SLlac-18在绵羊血平板上的形态
Fig.1 Morphology of L.brevis SLlac-18 on blood agar plate
2.1.2 短乳杆菌SLlac-18对小鼠体重和脏器指数的影响
实验期间,2组小鼠均未见行为异常和死亡现象,且毛色和精神状态均正常。由表2可知,实验7 d和14 d后,2组小鼠体重均增加,但无显著差异(P>0.05);此外,由表3可知,与对照组相比,实验组小鼠肝脏、左肾、右肾、脾脏指数均无显著变化(P>0.05)。
表2 灌胃短乳杆菌SLlac-18对小鼠体重的影响
Table 2 Effects of L.brevis SLlac-18 on weight of mice by gavage

时间/d对照组/g实验组/g130.90±0.83a31.04±0.76a734.80±1.32a34.96±1.11a1437.78±1.29a38.02±1.10a
注:相同小写字母表示组间无显著性差异(P>0.05)(下同)。
表3 灌胃短乳杆菌SLlac-18对小鼠脏器指数的影响
Table 3 Effects of L.brevis SLlac-18 on organ indexes of mice by gavage

项目对照组/%实验组/%肝脏指数6.03±0.45a5.56±0.52a左肾脏指数0.76±0.07a0.80±0.05a右肾脏指数0.76±0.06a0.81±0.04a脾脏指数0.40±0.09a0.44±0.02a
2.1.3 短乳杆菌SLlac-18对小鼠血常规指标的影响
如表4所示,通过测定不同组别小鼠血常规指标发现,与对照组相比,实验组小鼠红细胞数目、白细胞数目、淋巴细胞数目、血小板数目和血红蛋白浓度均无显著差异(P>0.05)。
表4 灌胃短乳杆菌SLlac-18对小鼠血常规指标的影响
Table 4 Effects of L.brevis SLlac-18 on blood routine indexes of mice by gavage

项目对照组实验组红细胞数目/(×1012个/L)10.04±0.24a9.82±0.58a血红蛋白/(g/dL)139.67±0.47a146.80±5.78a白细胞数目/(×109个/L)4.11±0.64a3.44±0.40a淋巴细胞数目/(×109个/L)3.09±0.54a2.34±0.43a血小板数目/(×109个/L)425.5±110.21a578.4±99.82a
2.1.4 短乳杆菌SLlac-18对小鼠肝脏和肾脏影响
如图2所示,实验组小鼠组织肝细胞排列紧密,整体形态正常,未见明显炎症细胞浸润,且肾小球、肾小管形态正常,未发现明显炎症、病灶区域,肝肾组织未见明显病变。

a-肝脏;b-肾脏
图2 短乳杆菌SLlac-18对小鼠肝脏和肾脏的影响
Fig.2 Effect of L.brevis SLlac-18 on liver and kidney in mice
2.2 短乳杆菌SLlac-18对高尿酸血症小鼠益生作用评价
2.2.1 短乳杆菌SLlac-18对小鼠体重及采食量的影响
如图3-a所示,用高嘌呤饲料和氧嗪酸钾药物干预的第1周,3组小鼠体重无显著差别(P>0.05),然而第2~3周与对照组相比,模型组和活菌组小鼠均出现体重减轻现象,尤其第3周不同组别小鼠体重差异显著(P<0.05),但相对于模型组而言,小鼠服用短乳杆菌SLlac-18后其体重下降趋势得到显著缓解(P<0.05)。此外,如图3-b所示,用高嘌呤饲料和氧嗪酸钾药物干预的第2~3周,模型组和活菌组小鼠采食量相比对照组均显著降低(P<0.05),但活菌组小鼠采食量显著高于模型组(P<0.05)。

a-小鼠体重;b-周均采食量
图3 不同处理组小鼠体重和周均采食量变化
Fig.3 Weight and average weekly food intake change of mice in different groups
注:****表示P<0.000 1;**表示P<0.05(下同)。
2.2.2 短乳杆菌SLlac-18对小鼠血液指标的影响
如图4-a所示,高尿酸血症模型组小鼠血清尿酸值为413.46 μmol/L,为对照组的1.53倍(P<0.05),而用短乳杆菌SLlac-18干预后,活菌组小鼠血清尿酸值为281.08 μmol/L,相较于模型组显著降低了32.02%(P<0.05);如图4-b所示,模型组小鼠血清中XOD活力为19.86 U/mL,是对照组的6.63倍(P<0.05),而用短乳杆菌SLlac-18干预后,活菌组小鼠血清XOD活力仅为3.82 U/mL,相比模型组降低80.77%(P<0.05),几乎接近于对照组水平。可见,短乳杆菌SLlac-18具有良好的降尿酸功效。

a-尿酸含量;b-XOD活力;c-BUN浓度;d-CRE含量;e-AST活力;f-ALT活力
图4 短乳杆菌SLlac-18对高尿酸血症小鼠血液指标的影响
Fig.4 Effects of L.brevis SLlac-18 on blood indexes of hyperuricemia mice

a-XOD活力;b-MDA含量;c-TNF-α质量浓度;d-IL-1β质量浓度
图5 短乳杆菌SLlac-18对高尿酸血症小鼠肝脏指标的影响
Fig.5 Effects of L.brevis SLlac-18 on liver indexes of hyperuricemia mice
如图4-c~图4-f所示,相比对照组,模型组小鼠血清中肾脏炎症指标,即BUN和CRE浓度,分别显著升高至20.04 mmol/L和174.47 μmol/L(P<0.05),肝脏炎症指标即AST和ALT活力分别显著提高至53.06 U/g prot和56.03 U/g prot(P<0.05),而用短乳杆菌SLlac-18干预后,小鼠血清中BUN和CRE浓度为10.62 mmol/L和96.54 μmol/L,相较于模型组分别显著降低47%和44.67%(P<0.05);而AST和ALT活力为27.37 U/g prot和17.05 U/g prot,比模型组显著降低48.42%和69.57%(P<0.05)。可见,短乳杆菌SLlac-18对高尿酸血症小鼠肝肾功能具有一定保护作用。
2.2.3 短乳杆菌SLlac-18对小鼠肝脏指标的影响
如图5-a所示,高尿酸血症模型组小鼠肝脏XOD活力为89.47 U/g,相对于对照组而言显著升高(P<0.05),而用短乳杆菌SLlac-18干预后,活菌组小鼠肝脏XOD活力为32.76 U/g,相较于模型组显著降低63.38%(P<0.05);此外,图5-b~图5-d结果表明,高尿酸血症模型组小鼠肝脏中炎症相关指标,即MDA含量、TNF-α和IL-1β质量浓度分别为33.10 mg prot、451.45 pg/mL和58.64 pg/mL,相较于对照组显著上升(P<0.05),而在活菌组小鼠肝脏中MDA含量为18.71 mg prot,相比模型组显著下降43.47%(P<0.05),而TNF-α质量浓度为416.81 pg/mL,显著下降7.67%(P<0.05)。
2.2.4 短乳杆菌SLlac-18对小鼠肾脏指标的影响
如图6所示,高尿酸血症模型组小鼠肾脏中炎症相关指标MDA含量、TNF-α和IL-1β质量浓度分别为7.63 mg prot、238.16 pg/mL和84.27 pg/mL,相较于对照组显著上升(P<0.05),而在活菌组小鼠肾脏中MDA含量为4.53 mg prot,相比于模型组显著下降40.63%(P<0.05),而TNF-α质量浓度为214.75 pg/mL,显著下降9.83%(P<0.05)。

a-MDA含量;b-TNF-α质量浓度;c-IL-1β质量浓度
图6 短乳杆菌SLlac-18对高尿酸血症小鼠肾脏指标的影响
Fig.6 Effects of L.brevis SLlac-18 on renal indexes of hyperuricemia mice

a-对照组肝脏;b-模型组肝脏;c-活菌组肝脏;d-对照组肾脏;e-模型组肾脏;f-活菌组肾脏
图7 短乳杆菌SLlac-18对高尿酸血症小鼠肝肾组织病理学影响
Fig.7 Effects of L.brevis SLlac-18 on liver and renal pathological changes in hyperuricemia mice.
2.2.5 短乳杆菌SLlac-18对小鼠肝脏和肾脏组织病理学影响
如图7-a所示,对照组小鼠肝小叶结构清晰,肝细胞胞质丰富、形态结构无明显异常。相比之下,高尿酸血症模型组小鼠肝细胞出现肿胀现象和气球状样变,出现炎性细胞浸润(图7-b)。而活菌组小鼠肝脏较模型组相比,虽仍有部分炎症浸润,但肝小叶结构相对清晰,肝板排列相对整齐,肝细胞胞质丰富、形态结构基本正常(图7-c)。
如图7-d所示,对照组小鼠肾脏组织中肾小球和肾小管结构完整,未见明显炎症和病灶区域。与其相比,高尿酸血症模型组小鼠肾脏组织中肾小管结构紊乱且出现肿胀现象,肾小球硬化固缩损伤明显,可见炎症细胞浸润(图7-e)。而活菌组小鼠肾脏较模型组相比虽仍可见炎症细胞浸润,但肾小管和肾小球结构损伤程度较轻,肾小球仅出现轻度固缩(图7-f)。
2.2.6 短乳杆菌SLlac-18对肾脏中GLUT9和NPT1蛋白表达水平的影响
如图8所示,模型组小鼠肾脏中GLUT9的基因及蛋白表达水平显著高于对照组(P<0.05),而用短乳杆菌SLlac-18干预后,活菌组小鼠肾脏GLUT9的表达量相比模型组下降23.74%;与此相反,模型组小鼠肾脏中NPT1的基因及蛋白表达水平相比对照组显著下降(P<0.01),而用短乳杆菌SLlac-18干预后,活菌组小鼠肾脏NPT1的表达量相比模型组升高23.68%。

a-GLUT9 mRNA表达水平; b-NPT1 mRNA表达水平; c-GLUT9和NPT1蛋白表达水平
图8 短乳杆菌SLlac-18对肾脏中GLUT9和NPT1蛋白表达水平的影响
Fig.8 Effects of L.brevis SLlac-18 on the expression levels of GLUT9 and NPT1 proteins in renal
注:***表示P<0.001。
3 结论与讨论
近几年,益生菌对高尿酸血症的治疗作用被相继报道,而益生菌发挥相应的益生功能需能够耐酸、耐胆盐、对抗生素具有敏感性且无溶血活性[14]。本课题组前期研究发现短乳杆菌SLlac-18具有良好的耐酸、耐胆盐及胃肠道耐受等特性,且对4种常见抗生素具有敏感性[12],本研究对其溶血活性进行检测发现,短乳杆菌SLlac-18不具有溶血性。口服毒性实验是检验益生菌是否安全的常用方法[15]。本研究发现,小鼠口服短乳杆菌SLlac-18后,其体重、脏器指数、血常规指标以及肝肾组织形态相比对照组未见异常,表明短乳杆菌SLlac-18无急性致病性,具有良好的安全性。
高尿酸血症主要表现为尿酸合成过多和排泄不足[16],而乳酸菌可通过抑制尿酸生成过程中的XOD活力、参与尿酸降解酶的合成以及减少肠道上皮细胞对嘌呤类物质的吸收等多种方式降低宿主尿酸水平,从而对高尿酸血症起到减缓作用[17]。本研究发现短乳杆菌SLlac-18可将高尿酸血症小鼠血清尿酸水平降低32.02%,高于WANG等[9]从酸菜中所分离得到的短乳杆菌DM9218,其血清尿酸降解率仅有20%。NI等[18]研究发现,鼠李糖乳酪杆菌R31、R28-1和罗伊氏粘液乳杆菌L20M3可通过调节肠道菌群,提高其代谢产物即短链脂肪酸的表达水平进而有效抑制血清和肝脏中XOD活力,降低血清尿酸水平;而LEE等[8]研究发现,短乳杆菌MJM60390可使宿主体内丁酸盐的表达量升高,由此推测短乳杆菌SLlac-18可能通过重构高尿酸血症小鼠肠道菌群结构,增加产短链脂肪酸的菌群丰度,提高短链脂肪酸的水平进而对XOD活力产生抑制作用,降低血清尿酸水平。
慢性炎症反应是高尿酸血症典型的病理学特征[19]。研究发现,尿酸过高会导致宿主肠道菌群失衡以及肠道渗透性增加,而肠道菌群所产生的有害代谢产物如脂多糖含量也明显升高,当其转移至血液中后,可引发肝脏和肾脏产生相关炎症[20]。乳酸菌可以通过调节肠道菌群平衡,抑制相关炎症因子的产生进而调节宿主体内尿酸水平。如SHI等[21]研究发现,植物乳植杆菌LLY-606可通过调节宿主肠道菌群,提高有益菌(如植物乳植杆菌和阿克曼菌等)表达丰度,有效降低高尿酸血症小鼠血清中脂多糖、BUN及CRE的含量,抑制肝肾组织中炎症因子TNF-α和IL-1β表达水平,进而促进宿主血清尿酸的代谢,降低其尿酸水平。此外,WANG等[22]研究结果表明,植物乳植杆菌YU28同样可以修复高尿酸血症模型小鼠肠道菌群结构和功能,降低其血清中脂多糖含量和炎症因子IL-1β表达水平,有效缓解因尿酸过高而引起的宿主肝肾损伤。本研究发现,短乳杆菌SLlac-18可降低高尿酸血症小鼠体内尿酸含量,并显著抑制肝肾组织炎症因子表达水平,这可能与该菌株对宿主肠道菌群的调节作用以及对肠屏障的保护功能有关。
尿酸在肾脏中的重吸收和分泌取决于各种尿酸转运蛋白[23]。FU等[24]研究发现,植物乳植杆菌SQ001可通过上调ABCG2表达并下调GLUT9水平,促进高尿酸血症小鼠的尿酸排泄;张书灵等[25]的研究结果表明,对尿酸代谢具有良好调节作用的格氏乳杆菌CCFM1346同样可以有效降低高尿酸血症模型组小鼠肾脏中GLUT9的表达水平。本研究结果分析发现,相比对照组,模型组小鼠肾脏中重吸收蛋白GLUT9呈显著上升趋势,而尿酸分泌转运蛋白NPT1则呈显著下降趋势,但短乳杆菌SLlac-18可有效调节二者的表达量,使其均接近于对照组水平,这与前人的研究结果相近,表明短乳杆菌SLlac-18可能通过调节肾脏尿酸重吸收转运蛋白和排泄蛋白的表达量,进而调节宿主体内尿酸水平。
综上,短乳杆菌SLlac-18具有良好的安全性,可通过多种方式对高尿酸血症小鼠发挥益生功能,缓解相关病症,后续将继续深入研究该菌株对高尿酸血症小鼠肠屏障的保护作用,并对短乳杆菌SLlac-18可能参与的宿主体内相关代谢通路进行探索,进一步研究关键菌株和关键代谢物的关联性以及对尿酸的调控作用,深入探讨短乳杆菌SLlac-18的降尿酸机制。
[1] JUNG S W, KIM S M, KIM Y G, et al.Uric acid and inflammation in kidney disease[J].American Journal of Physiology.Renal Physiology, 2020, 318(6):F1327-F1340.
[2] 陈柔柔, 刘煜.高尿酸血症及痛风与肠道菌群相关性的研究进展[J].南京医科大学学报(自然科学版), 2020, 40(10):1560-1564.CHEN R R, LIU Y.Research update on the association of gut microbiota with hyperuricemia and gout[J].Journal of Nanjing Medical University (Natural Sciences), 2020, 40(10):1560-1564.
[3] WANG J, CHEN Y, ZHONG H, et al.The gut microbiota as a target to control hyperuricemia pathogenesis:Potential mechanisms and therapeutic strategies[J].Critical Reviews in Food Science and Nutrition, 2022, 62(14):3979-3989.
[4] PASCART T, RICHETTE P.Investigational drugs for hyperuricemia, an update on recent developments[J].Expert Opinion on Investigational Drugs, 2018, 27(5):437-444.
[5] CHIEN C Y, CHIEN Y J, LIN Y H, et al.Supplementation of Lactobacillus plantarum (TCI227) prevented potassium-oxonate-induced hyperuricemia in rats[J].Nutrients, 2022, 14(22):4832.
[6] CAO J Y, WANG T, LIU Y S, et al.Lactobacillus fermentum F40-4 ameliorates hyperuricemia by modulating the gut microbiota and alleviating inflammation in mice[J].Food &Function, 2023, 14(7):3259-3268.
[7] HAMADA T, HISATOME I, WAKIMIZU T, et al.Lactobacillus gasseri PA-3 reduces serum uric acid levels in patients with marginal hyperuricemia[J].Nucleosides, Nucleotides &Nucleic Acids, 2022, 41(4):361-369.
[8] LEE Y J, KIM N, WERLINGER P, et al.Probiotic characterization of Lactobacillus brevis MJM60390 and in vivo assessment of its antihyperuricemic activity[J].Journal of Medicinal Food, 2022, 25(4):367-380.
[9] WANG H N, MEI L, DENG Y, et al.Lactobacillus brevis DM9218 ameliorates fructose-induced hyperuricemia through inosine degradation and manipulation of intestinal dysbiosis[J].Nutrition, 2019, 62:63-73.
[10] CANNON J P, LEE T A, BOLANOS J T, et al.Pathogenic relevance of Lactobacillus:A retrospective review of over 200 cases[J].European Journal of Clinical Microbiology and Infectious Diseases, 2005, 24(1):31-40.
[11] KOTHARI D, PATEL S, KIM S K.Probiotic supplements might not be universally-effective and safe:A review[J].Biomedicine &Pharmacotherapy, 2019, 111:537-547.
[12] 李杰, 张鹏霞, 周健, 等.传统泡菜中高效降解核苷乳酸菌的筛选及其特性研究[J].食品与发酵工业, 2024, 50(12):227-233.LI J, ZHANG P X, ZHOU J, et al.Isolation of efficient nucleoside-degrading lactic acid bacteria from traditional pickles and their probiotic properties[J].Food and Fermentation Industries, 2024, 50(12):227-233.
[13] 贾盛, 候萌, 陈伟丽, 等.一株羊源巨大芽孢杆菌BM24的分离鉴定及安全性评价[J].动物营养学报, 2024, 36(9):6083-6094.JIA S, HOU M, CHEN W L, et al.Isolation, identification and safety evaluation of a sheep-derived Bacillus megaterium BM24[J].Chinese Journal of Animal Nutrition, 2024, 36(9):6083-6094.
[14] BINDA S, HILL C, JOHANSEN E, et al.Criteria to qualify microorganisms as “probiotic” in foods and dietary supplements[J].Frontiers in Microbiology, 2020, 11:1662.
[15] 冯媛媛, 乔琳, 姚宏明, 等.益生菌安全性和有效性评价方法的研究进展[J].中国畜牧兽医, 2017, 44(7):2022-2032.FENG Y Y, QIAO L, YAO H M, et al.Research progress on the evaluation methods of safety and efficacy of probiotics[J].China Animal Husbandry &Veterinary Medicine, 2017, 44(7):2022-2032.
[16] MAIUOLO J, OPPEDISANO F, GRATTERI S, et al.Regulation of uric acid metabolism and excretion[J].International Journal of Cardiology, 2016, 213:8-14.
[17] 杨新如, 唐甲越, 曾小群, 等.益生菌缓解高尿酸血症:研究现状、作用机制及面临的挑战[J].食品工业科技, 2024, 45(20):415-425.YANG X R, TANG J Y, ZENG X Q, et al.Probiotics in alleviating hyperuricemia:Research status, mechanism of action and challenges[J].Science and Technology of Food Industry, 2024, 45(20):415-425.
[18] NI C X, LI X, WANG L L, et al.Lactic acid bacteria strains relieve hyperuricaemia by suppressing xanthine oxidase activity via a short-chain fatty acid-dependent mechanism[J].Food &Function, 2021, 12(15):7054-7067.
[19] ZHOU Y, ZHAO M C, PU Z Y, et al.Relationship between oxidative stress and inflammation in hyperuricemia:Analysis based on asymptomatic young patients with primary hyperuricemia[J].Medicine, 2018, 97(49):e13108.
[20] XU D X, LYU Q L, WANG X F, et al.Hyperuricemia is associated with impaired intestinal permeability in mice[J].American Journal of Physiology.Gastrointestinal and Liver Physiology, 2019, 317(4):G484-G492.
[21] SHI R J, YE J, FAN H, et al.Lactobacillus plantarum LLY-606 supplementation ameliorates hyperuricemia via modulating intestinal homeostasis and relieving inflammation[J].Food &Function, 2023, 14(12):5663-5677.
[22] WANG Q X, LIANG J R, ZOU Q H, et al. Tryptophan metabolism-regulating probiotics alleviate hyperuricemia by protecting the gut barrier integrity and enhancing colonic uric acid excretion[J]. Journal of Agricultural and Food Chemistry, 2024, 72(48):26746-26761.
[23] 辛家东, 周嘉宝, 吴志远, 等.尿酸排泄及其相关转运蛋白在高尿酸血症中的研究进展[J].中国全科医学, 2023, 26(15):1916-1922.XIN J D, ZHOU J B, WU Z Y, et al.Advances in urate excretion and urate transporters in hyperuricemia[J].Chinese General Practice, 2023, 26(15):1916-1922.
[24] FU Y, LUO X D, LI J Z, et al. Host-derived Lactobacillus plantarum alleviates hyperuricemia by improving gut microbial community and hydrolase-mediated degradation of purine nucleosides[J]. eLife, 2024, 13: e100068.
[25] 张书灵, 唐鑫, 毛丙永, 等.格氏乳杆菌CCFM1346通过调节尿酸代谢和改善肾脏炎症缓解小鼠的高尿酸血症[J].食品与发酵工业, 2025, 51(3):52-57.ZHANG S L, TANG X, MAO B Y, et al.Lactobacillus gasseri CCFM1346 alleviates hyperuricemia in mice by regulating uric acid metabolism and improving kidney inflammation[J].Food and Fermentation Industries, 2025, 51(3):52-57.